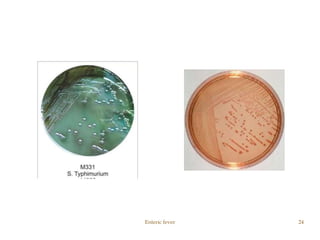
Enteric fever 24

This document provides information about enteric fever (typhoid fever) in 43 sections. It discusses the history, causative agents, transmission, signs and symptoms, diagnosis, treatment and prevention. Regarding diagnosis, it describes tests such as blood, stool and urine cultures, the Widal test and slide agglutination. Salmonella typhi and paratyphi cause typhoid and paratyphoid fever respectively by ingesting contaminated food or water. Complications can include sepsis and meningitis. Antibiotics are used for treatment, but drug resistance has emerged. Vaccines provide protection against the disease.